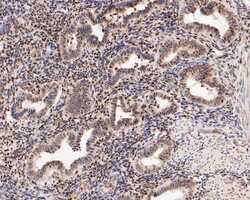

Antibody data
- Antibody Data
- Antigen structure
- References [0]
- Comments [0]
- Validations
- Western blot [1]
- Immunocytochemistry [4]
- Immunohistochemistry [9]
- Flow cytometry [2]
Submit
Validation data
Reference
Comment
Report error
- Product number
- PA5-119697 - Provider product page

- Provider
- Invitrogen Antibodies
- Product name
- LMO2 Polyclonal Antibody
- Antibody type
- Polyclonal
- Antigen
- Synthetic peptide
- Description
- Positive Control: Daudi cell lysates, EA.hy926, RAW264.7, SW620, rat womb tissue, human tonsil tissue, human bone marrow tissue, human womb tissue, mouse brain tissue. Subcellular Location: Nucleus.
- Reactivity
- Human, Mouse, Rat
- Host
- Rabbit
- Isotype
- IgG
- Vial size
- 100 μL
- Concentration
- 1 mg/mL
- Storage
- Store at 4°C short term. For long term storage, store at -20°C, avoiding freeze/thaw cycles.
No comments: Submit comment
Supportive validation
- Submitted by
- Invitrogen Antibodies (provider)
- Main image

- Experimental details
- Western blot analysis of LMO2 on Daudi cell lysate. Proteins were transferred to a PVDF membrane and blocked with 5% BSA in PBS for 1 hour at room temperature. LMO2 Polyclonal Antibody (Product # PA5-119697) at 1:1,000 was used in 5% BSA at room temperature for 2 hours. Goat Anti-Rabbit IgG - HRP Secondary Antibody at 1:5,000 dilution was used for 1 hour at room temperature.
Supportive validation
- Submitted by
- Invitrogen Antibodies (provider)
- Main image

- Experimental details
- Immunocytochemistry-Immunofluorescence analysis of of LMO2 in SW620 cells (green). Formalin fixed cells were permeabilized with 0.1% Triton X-100 in TBS for 10 minutes at room temperature and blocked with 1% Blocker BSA for 15 minutes at room temperature. Cells were probed with LMO2 Polyclonal Antibody (Product # PA5-119697) at a dilution of 1:50 for 1 hour at room temperature, washed with PBS. Alexa Fluor 488 Goat anti-Rabbit IgG was used as the secondary antibody at 1:1,000 dilution. The nuclear counter stain is DAPI (blue).
- Submitted by
- Invitrogen Antibodies (provider)
- Main image

- Experimental details
- Immunocytochemistry-Immunofluorescence analysis of of LMO2 in RAW264.7 cells (green). Formalin fixed cells were permeabilized with 0.1% Triton X-100 in TBS for 10 minutes at room temperature and blocked with 1% Blocker BSA for 15 minutes at room temperature. Cells were probed with LMO2 Polyclonal Antibody (Product # PA5-119697) at a dilution of 1:100 for 1 hour at room temperature, washed with PBS. Alexa Fluor 488 Goat anti-Rabbit IgG was used as the secondary antibody at 1:1,000 dilution. The nuclear counter stain is DAPI (blue).
- Submitted by
- Invitrogen Antibodies (provider)
- Main image

- Experimental details
- Immunocytochemistry-Immunofluorescence analysis of of LMO2 in SW620 cells (green). Formalin fixed cells were permeabilized with 0.1% Triton X-100 in TBS for 10 minutes at room temperature and blocked with 1% Blocker BSA for 15 minutes at room temperature. Cells were probed with LMO2 Polyclonal Antibody (Product # PA5-119697) at a dilution of 1:50 for 1 hour at room temperature, washed with PBS. Alexa Fluor 488 Goat anti-Rabbit IgG was used as the secondary antibody at 1:1,000 dilution. The nuclear counter stain is DAPI (blue).
- Submitted by
- Invitrogen Antibodies (provider)
- Main image

- Experimental details
- Immunocytochemistry-Immunofluorescence analysis of of LMO2 in EA.hy926 cells (green). Formalin fixed cells were permeabilized with 0.1% Triton X-100 in TBS for 10 minutes at room temperature and blocked with 1% Blocker BSA for 15 minutes at room temperature. Cells were probed with LMO2 Polyclonal Antibody (Product # PA5-119697) at a dilution of 1:100 for 1 hour at room temperature, washed with PBS. Alexa Fluor 488 Goat anti-Rabbit IgG was used as the secondary antibody at 1:1,000 dilution. The nuclear counter stain is DAPI (blue).
Supportive validation
- Submitted by
- Invitrogen Antibodies (provider)
- Main image

- Experimental details
- Immunohistochemistry (Paraffin) analysis of paraffin-embedded rat womb tissue using LMO2 Polyclonal Antibody (Product # PA5-119697). The section was pre-treated using heat mediated antigen retrieval with sodium citrate buffer (pH 6.0) for 20 minutes. The tissues were blocked in 5% BSA for 30 minutes at room temperature, washed with ddH2O and PBS, and then probed with the LMO2 antibody at a dilution of 1:200 for 30 minutes at room temperature. The detection was performed using an HRP conjugated compact polymer system. DAB was used as the chromogen. Tissues were counterstained with hematoxylin and mounted with DPX.
- Submitted by
- Invitrogen Antibodies (provider)
- Main image

- Experimental details
- Immunohistochemistry (Paraffin) analysis of paraffin-embedded human tonsil tissue using LMO2 Polyclonal Antibody (Product # PA5-119697). The section was pre-treated using heat mediated antigen retrieval with sodium citrate buffer (pH 6.0) for 20 minutes. The tissues were blocked in 5% BSA for 30 minutes at room temperature, washed with ddH2O and PBS, and then probed with the LMO2 antibody at a dilution of 1:200 for 30 minutes at room temperature. The detection was performed using an HRP conjugated compact polymer system. DAB was used as the chromogen. Tissues were counterstained with hematoxylin and mounted with DPX.
- Submitted by
- Invitrogen Antibodies (provider)
- Main image

- Experimental details
- Immunohistochemistry (Paraffin) analysis of paraffin-embedded human bone marrow tissue using LMO2 Polyclonal Antibody (Product # PA5-119697). The section was pre-treated using heat mediated antigen retrieval with sodium citrate buffer (pH 6.0) for 20 minutes. The tissues were blocked in 5% BSA for 30 minutes at room temperature, washed with ddH2O and PBS, and then probed with the LMO2 antibody at a dilution of 1:200 for 30 minutes at room temperature. The detection was performed using an HRP conjugated compact polymer system. DAB was used as the chromogen. Tissues were counterstained with hematoxylin and mounted with DPX.
- Submitted by
- Invitrogen Antibodies (provider)
- Main image

- Experimental details
- Immunohistochemistry (Paraffin) analysis of paraffin-embedded human womb tissue using LMO2 Polyclonal Antibody (Product # PA5-119697). The section was pre-treated using heat mediated antigen retrieval with sodium citrate buffer (pH 6.0) for 20 minutes. The tissues were blocked in 5% BSA for 30 minutes at room temperature, washed with ddH2O and PBS, and then probed with the LMO2 antibody at a dilution of 1:200 for 30 minutes at room temperature. The detection was performed using an HRP conjugated compact polymer system. DAB was used as the chromogen. Tissues were counterstained with hematoxylin and mounted with DPX.
- Submitted by
- Invitrogen Antibodies (provider)
- Main image

- Experimental details
- Immunohistochemistry (Paraffin) analysis of paraffin-embedded mouse brain tissue using LMO2 Polyclonal Antibody (Product # PA5-119697). The section was pre-treated using heat mediated antigen retrieval with sodium citrate buffer (pH 6.0) for 20 minutes. The tissues were blocked in 5% BSA for 30 minutes at room temperature, washed with ddH2O and PBS, and then probed with the LMO2 antibody at a dilution of 1:200 for 30 minutes at room temperature. The detection was performed using an HRP conjugated compact polymer system. DAB was used as the chromogen. Tissues were counterstained with hematoxylin and mounted with DPX.
- Submitted by
- Invitrogen Antibodies (provider)
- Main image

- Experimental details
- Immunohistochemistry (Paraffin) analysis of paraffin-embedded rat womb tissue using LMO2 Polyclonal Antibody (Product # PA5-119697). The section was pre-treated using heat mediated antigen retrieval with sodium citrate buffer (pH 6.0) for 20 minutes. The tissues were blocked in 5% BSA for 30 minutes at room temperature, washed with ddH2O and PBS, and then probed with the LMO2 antibody at a dilution of 1:200 for 30 minutes at room temperature. The detection was performed using an HRP conjugated compact polymer system. DAB was used as the chromogen. Tissues were counterstained with hematoxylin and mounted with DPX.
- Submitted by
- Invitrogen Antibodies (provider)
- Main image

- Experimental details
- Immunohistochemistry (Paraffin) analysis of paraffin-embedded human bone marrow tissue using LMO2 Polyclonal Antibody (Product # PA5-119697). The section was pre-treated using heat mediated antigen retrieval with sodium citrate buffer (pH 6.0) for 20 minutes. The tissues were blocked in 5% BSA for 30 minutes at room temperature, washed with ddH2O and PBS, and then probed with the LMO2 antibody at a dilution of 1:200 for 30 minutes at room temperature. The detection was performed using an HRP conjugated compact polymer system. DAB was used as the chromogen. Tissues were counterstained with hematoxylin and mounted with DPX.
- Submitted by
- Invitrogen Antibodies (provider)
- Main image
- Experimental details
- Immunohistochemistry (Paraffin) analysis of paraffin-embedded human womb tissue using LMO2 Polyclonal Antibody (Product # PA5-119697). The section was pre-treated using heat mediated antigen retrieval with sodium citrate buffer (pH 6.0) for 20 minutes. The tissues were blocked in 5% BSA for 30 minutes at room temperature, washed with ddH2O and PBS, and then probed with the LMO2 antibody at a dilution of 1:200 for 30 minutes at room temperature. The detection was performed using an HRP conjugated compact polymer system. DAB was used as the chromogen. Tissues were counterstained with hematoxylin and mounted with DPX.
- Submitted by
- Invitrogen Antibodies (provider)
- Main image

- Experimental details
- Immunohistochemistry (Paraffin) analysis of paraffin-embedded mouse brain tissue using LMO2 Polyclonal Antibody (Product # PA5-119697). The section was pre-treated using heat mediated antigen retrieval with sodium citrate buffer (pH 6.0) for 20 minutes. The tissues were blocked in 5% BSA for 30 minutes at room temperature, washed with ddH2O and PBS, and then probed with the LMO2 antibody at a dilution of 1:200 for 30 minutes at room temperature. The detection was performed using an HRP conjugated compact polymer system. DAB was used as the chromogen. Tissues were counterstained with hematoxylin and mounted with DPX.
Supportive validation
- Submitted by
- Invitrogen Antibodies (provider)
- Main image

- Experimental details
- Flow Cytometry analysis of LMO2 in SW620 cells using LMO2 Polyclonal Antibody (Product # PA5-119697) at 1:50 (red). After incubation of the primary antibody at room temperature for an hour, the cells were stained with a Alexa Fluor 488-conjugated Goat anti-Rabbit IgG Secondary antibody at 1:1,000 dilution for 30 minutes. Unlabelled sample was used as a control (cells without incubation with primary antibody; black).
- Submitted by
- Invitrogen Antibodies (provider)
- Main image

- Experimental details
- Flow Cytometry analysis of LMO2 in SW620 cells using LMO2 Polyclonal Antibody (Product # PA5-119697) at 1:50 (red). After incubation of the primary antibody at room temperature for an hour, the cells were stained with a Alexa Fluor 488-conjugated Goat anti-Rabbit IgG Secondary antibody at 1:1,000 dilution for 30 minutes. Unlabelled sample was used as a control (cells without incubation with primary antibody; black).